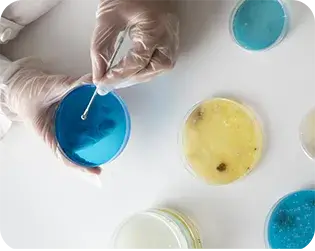
Servicios

Laboratorio RAGA surge en 2024 como el resultado de una nueva generación apasionada por la ciencia y la salud. Fundado por un profesional con sólida formación en microbiología y un legado familiar en el ámbito clínico, es el primer laboratorio en su familia enfocado exclusivamente en el análisis microbiológico de alimentos.
Comprometidos con la calidad, la inocuidad y el cumplimiento normativo, utilizamos tecnología de vanguardia y contamos con un equipo altamente capacitado para ofrecer resultados confiables, rápidos y alineados con los más altos estándares nacionales e internacionales.
En RAGA Laboratorio, la ciencia avanza cuidando la salud y la calidad de los alimentos que llegan a tu mesa.

Realizamos pruebas específicas y microbiología tradicional para la detección precisa de los principales patógenos, aplicando metodologías confiables y actualizadas que garantizan resultados certeros en el diagnóstico microbiológico.
Contamos con equipos de última generación, metodologías actualizadas y un equipo de profesionales altamente capacitado para lograr la detección de microorganismos patógenos como Salmonella, Listeria, E. coli y más. Cumplimos con normativas nacionales e internacionales y además brindamos resultados confiables en el menor tiempo posible.

Tu tranquilidad empieza con alimentos seguros.
